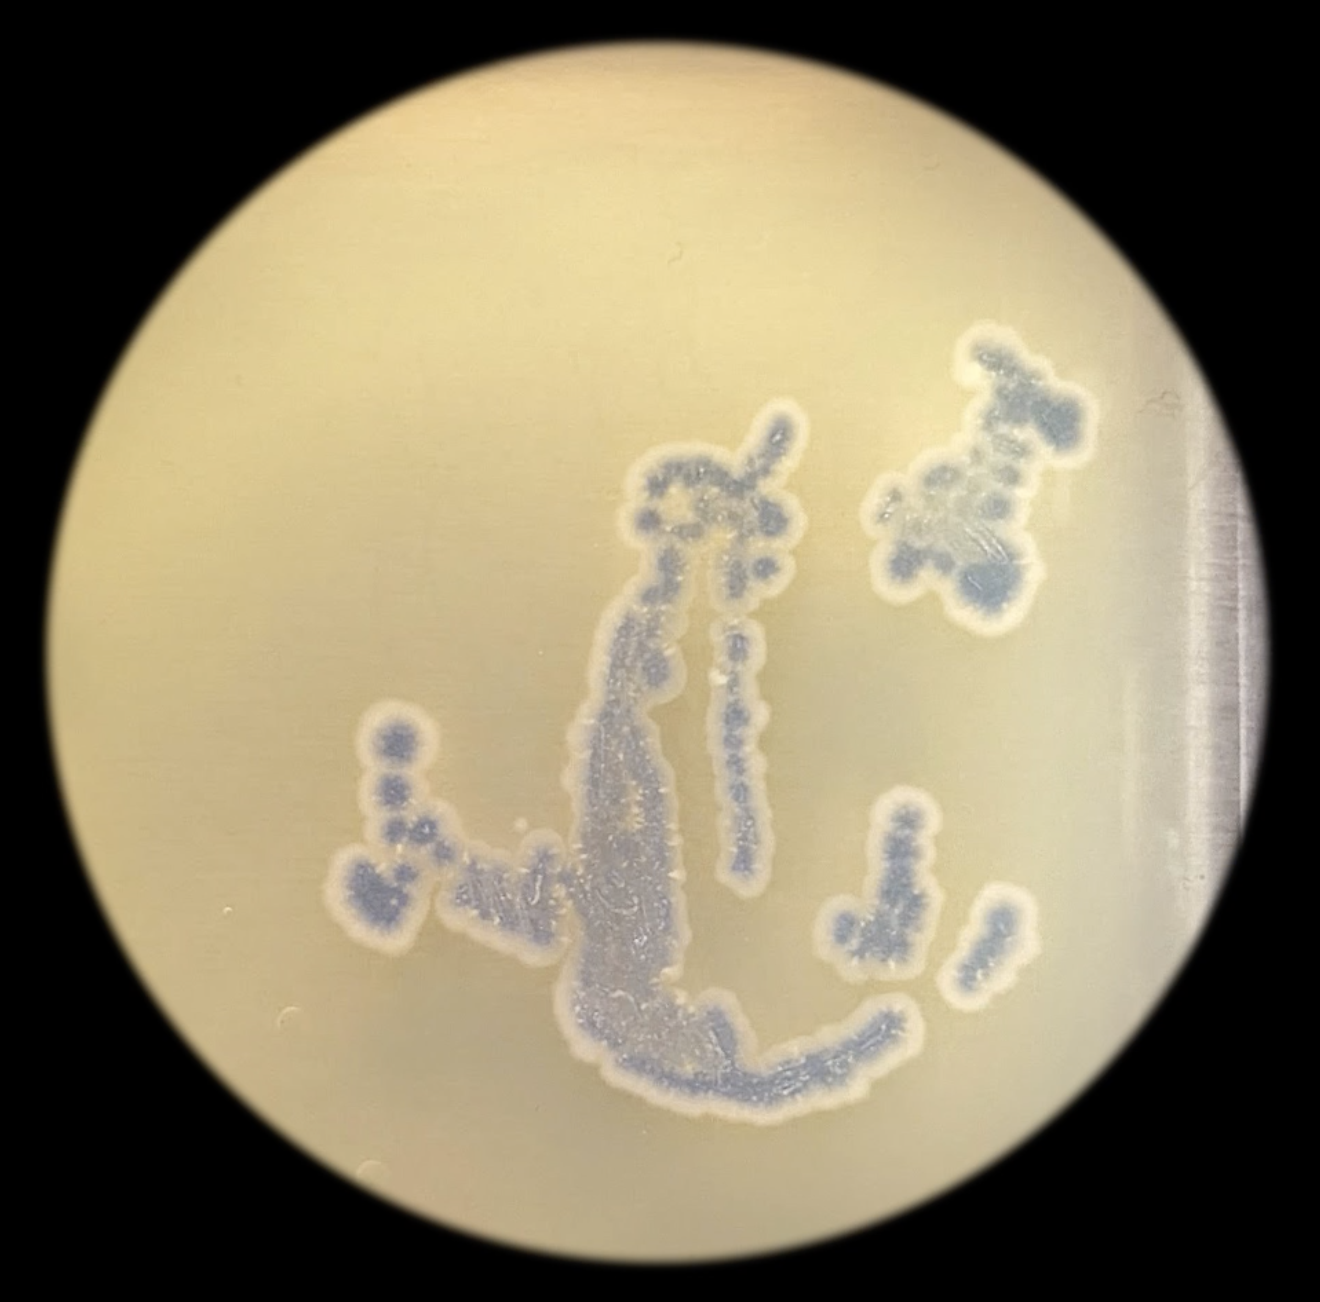

bacterial printing project Project Overview The most exciting thing to me during this first project in the lab was finding…
My absolute favorite thing to photograph is tree branches in the winter when you can really see them twisting and tangling. This is a mini display of interspecies connectivity (?).
to miss this is not useless, 2025
timelapse of genetically engineered e. coli growth; series of inscriptions in RFP e. coli, amajlime e.coli, rusted steel, rust print on cheesecloth
Nicholas Mittman, Interdisciplinary Sculpture, 2027 Interdisciplinary Sculpture major at MICA. Originally transferred from Harford Community College; Nicholas enjoys working with…
put your 50 word project sttement here
bacterial printing with multiple colors.
Biomorphic and technological design using RFP e. coli on agar
“Psychopomp”
Collaborative living animation
Caffenol 16mm film, performance, animation, genetically engineered E. coli.
Stencils of Mallorcan embroidery by Antonia Barceló Oliver, LB agar plates, gloves, tape, genetic engineered E.Coli.
put your 50 word project sttement here
put your 50 word project sttement here
using jelly printing techniques in the lab… and doing the things I wasn’t suppose to do
Do you remember carving little love hearts into a tree? This is like that, except for it’s carved out of inanimate material and then life is added into the wound. In this case the flesh like quality of the agar and red pigment of the Ecoli give it the feeling of a bloody wound.
For this project, I was thinking of the microcosmic vs. microcosmic. There is an uncountable amount of cells in a given spot of Ecoli on a Petri dish, similar to the amount of stars in the sky. I think of bacterial colonies as a little family and began thinking of the familial relationships inherent in horoscopes. My mother gave me my star sign: five little stars in a vast universe.
put your 50 word project sttement here
put your 50 word project sttement here
A speculative collaboration with bacteria to design a nightstand.
Stenciled ASCII image of two hands playing with string figures
put your 50 word project sttement here
What is the future of natural dyes? Can our clothes be dyed with bacteria? For the bacterial drawings project, I was interested in testing the potential of bacteria as a “natural” dye to see if it would dye natural fibers. Building connections with all natural beings, bacteria included, is a collaboration that I am passionate about for my material research in my practice.
“god’s eye / god in a seed” explores the intersections of microbial life, AI technology, the human hand, and theology. How do we interact with that we do not know? How do we interact with that which seems to know us too well?
Try to use the layering method to apply a second layer of color with a new kapton after the first layer of E.coli has already showed up the color.
put your 50 word project sttement here
Knowing that E.coli will gradually “disappear” after a while of growth (it is actually that the bacteria spread out on plate so the color fades out), I want to grasp and make art out of this characteristic. The 语气词, similar to interjections in English (I’m still trying to find the best translation), in Chinese language are always at the end of a sentence and all of them don’t have a tone, which is rare in Chinese because generally speaking every word has a tone. That makes 语气词 unremarkable and is easy to be ignored. So I want these words to be displayed in an already faded state.
Mimicking cave paintings with CRISPR and fluorescent red Ecoli.